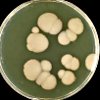

Запись
1500₽
+7(499 ..показать +7(499) 11-68-239+7(499) 521-27-51
МЦ Азбука Здоровья на Новокуркинском шоссе Москва; Новокуркинское шоссе, д. 31 ; м. Планерная
Запись
3500₽
+7(495 ..показать +7(499) 11-68-239+7(495) 105-96-79 +7(963) 699-66-55
МЦ Здоровье Основа Всего на Алабяна Москва; ул. Алабяна, д. 10, корп. 3 ; м. Сокол
Запись
7000₽
+7(495 ..показать +7(499) 11-68-239+7(495) 135-05-92
Дельта Клиник в Наставническом переулке Москва; Наставнический пер., д. 6 ; м. Курская
Запись
12000₽
+7(861 ..показать +7(499) 11-68-239+7(861) 238-86-02
Уро-Про на Яна Полуяна Краснодар; ул. Яна Полуяна, д. 51 ;
Запись
12000₽
+7(861 ..показать +7(499) 11-68-239+7(861) 238-86-02
Уро-Про на 40 лет Победы Краснодар; ул. 40 лет Победы, д. 108 ;
Запись
13000₽
+7(495 ..показать +7(499) 11-68-239+7(495) 432-22-56
Трит на Каширском шоссе Москва; Каширское шоссе, д. 51, корп. 3 ; м. Кантемировская
Запись
13000₽
+7(495 ..показать +7(499) 11-68-239+7(495) 432-22-56
Трит на Кантемировской Москва; ул. Кантемировская, д. 53, корп. 1 ; м. Кантемировская
Запись
15000₽
+7(499 ..показать +7(499) 11-68-239+7(499) 641-13-02
МедЦентрСервис в Черёмушках Москва; ул. Гарибальди, д. 36 ; м. Новые Черёмушки
Запись
15000₽
+7(499 ..показать +7(499) 11-68-239+7(499) 641-13-02
МедЦентрСервис в Южном Чертаново Москва; ул. Россошанская, д. 4, корп. 1 ; м. Улица Академика Янгеля
Запись
15000₽
+7(499 ..показать +7(499) 11-68-239+7(499) 641-13-02
МедЦентрСервис на Тверской-Ямской Москва; ул. 1-я Тверская-Ямская, д. 29 ; м. Белорусская
Запись
15000₽
+7(499 ..показать +7(499) 11-68-239+7(499) 519-39-77 +7(499) 641-13-02
МедЦентрСервис в Марьино Москва; ул. Новомарьинская, д. 32 ; м. Братиславская
Запись
15000₽
+7(499 ..показать +7(499) 11-68-239+7(499) 519-39-27 +7(499) 641-13-02
МедЦентрСервис в Отрадном Москва; ул. Пестеля, д. 11 ; м. Отрадное
Запись
15000₽
+7(499 ..показать +7(499) 11-68-239+7(499) 641-13-02
МедЦентрСервис в Митино Москва; ул. Митинская, д. 28, корп. 3 ; м. Митино
Запись
15000₽
+7(495 ..показать +7(499) 11-68-239+7(495) 431-42-42
МедЦентрСервис на Ленинградском проспекте Москва; Ленинградский пр-т, д. 67, корп. 1 ; м. Сокол
Запись
15000₽
+7(499 ..показать +7(499) 11-68-239+7(499) 519-39-85 +7(499) 641-13-02
МедЦентрСервис в Коньково Москва; ул. Миклухо-Маклая, д. 43 ; м. Беляево
Запись
15000₽
+7(499 ..показать +7(499) 11-68-239+7(499) 641-13-02
МедЦентрСервис в Медведково Москва; ул. Полярная, д. 32 ; м. Медведково
Запись
15000₽
+7(495 ..показать +7(499) 11-68-239+7(495) 431-42-42 +7(495) 324-88-22
МедЦентрСервис в Солнцево Москва; ул. Главмосстроя, д. 7 ; м. Румянцево
Запись
23660₽
+7(499 ..показать +7(499) 11-68-239+7(499) 490-89-29
Бест Клиник в Спартаковском переулке Москва; Спартаковский пер., д. 2, стр. 11 ; м. Красносельская
Запись
23660₽
+7(499 ..показать +7(499) 11-68-239+7(499) 490-89-29
Бест Клиник на Новочерёмушкинской Москва; ул. Новочерёмушкинская, д. 34, корп. 2 ; м. Профсоюзная
Запись
25000₽
+7(495 ..показать +7(499) 11-68-239+7(495) 248-00-33 +7(968) 043-31-33
IQ-clinic на Бескудниковском бульваре Москва; Бескудниковский б-р, д. 2, корп. 1 ; м. Лихоборы
Ещё клиник - 35 . Используйте фильтры